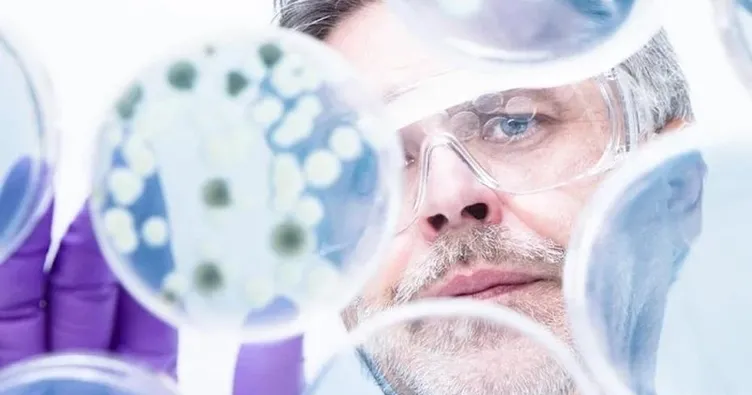

Bilim insanları kanser hücrelerini yok etmek için yeni bir yöntem keşfetti. Söz konusu yöntemde, aminosiyanin moleküllerinin yakın kızılötesi ışıkla uyarılması, bunların kanser hücresi zarlarını parçalamaya yetecek kadar senkronize bir şekilde titreşmesine neden oluyor. Rice Üniversitesi, Texas A&M Üniversitesi ve Texas Üniversitesi'nden bir araştırma ekibi, yeni yaklaşımın, daha önce geliştirilen, sorunlu hücrelerin yapılarını parçalayabilen "feringa tipi motorlar" adlı başka bir tür kanser öldürücü moleküler sisteme kıyasla belirgin bir gelişme olduğunu vurguladı. Araştırmanın henüz ilk günleri olmasına rağmen söz konusu ilk bulgular oldukça umut verici olarak değerlendirildi. Bu aynı zamanda kanser hücrelerinin bir çeşit blokaj geliştirmede zorlanacağı türden bir biyomekanik yöntem.